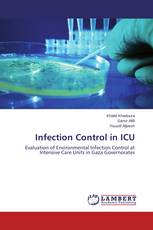
Infection Control in ICU

Sorry, Something is wrong with your request
Infection Control in ICU
Evaluation of Environmental Infection Control at Intensive Care Units in Gaza Governorates
Khalid Khadoura, Samir Afifi, Yousef Aljeesh - ISBN: 978-3-659-34527-2
Basic Thermodynamics
A Fundamentals of Thermodynamics
Harold Jan R. Terano, Radmar B. Tañamor - ISBN: 978-3-659-47807-9
Effect of gamma irradiation on the proximate of canned tomato paste
Rukhama Haq, Sidra Akram, Shagufta Naz - ISBN: 978-3-659-63084-2
Impact of pesticides on microorganisms in soils
An experimental approach for the assessment of pesticide effects on microorganisms in soils
M. Srinivasulu, G. Jaffer Mohiddin, V. Rangaswamy - ISBN: 978-3-659-45109-6
Urban Social Protection and Socio-Economic Empowerment of Women
Social Protection in the Informal Sector
Mulugeta Gadissa - ISBN: 978-3-659-41623-1
Academic Performance of Public and Private Schools
A Comparative Study
Aparajita Biswal, Sasmita Behera - ISBN: 978-3-659-47846-8
Effect of foliar spray of micronutrients on Alphonso mango
Tulsi Gurjar, N. L. Patel - ISBN: 978-3-659-47511-5